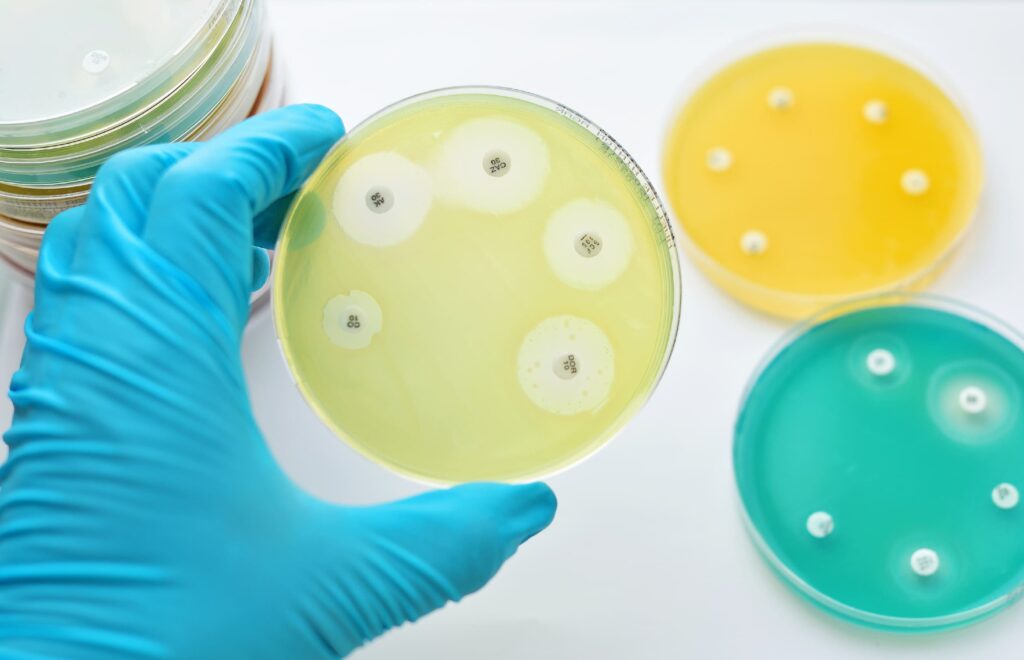

Antimicrobial Textile Testing: Methods, Standards, and Compliance Applications
Antimicrobial textile testing is a laboratory evaluation used to assess the effectiveness of antimicrobial treatments applied to textile materials. These treatments are designed to inhibit the growth of bacteria, fungi, and other microorganisms that can cause odors, material degradation, hygiene concerns, and potential health risks.
Antimicrobial finishes are widely used in apparel, medical textiles, home textiles, and industrial fabrics. To ensure product performance, safety, and regulatory compliance, antimicrobial claims must be supported by standardized testing results.
Understanding Antimicrobial Treatments in Textiles
Antimicrobial textiles are treated with chemical agents or engineered with functional materials that suppress microbial growth. Common antimicrobial technologies include:
- Silver-based compounds
- Quaternary ammonium salts
- Zinc-based additives
- Organic antimicrobial agents
- Bio-based antimicrobial finishes
These treatments are applied during fiber production, fabric finishing, coating, or padding processes.
Antimicrobial functionality is commonly introduced to achieve:
- Odor control in garments and sportswear
- Hygiene improvement in medical and healthcare textiles
- Mold and mildew resistance in home textiles
- Material protection in industrial fabrics
Because antimicrobial effectiveness can decrease over time due to washing, wear, and environmental exposure, laboratory testing is required to validate performance under controlled conditions.
Why Antimicrobial Textile Testing Is Required
Antimicrobial textile testing supports both performance verification and regulatory compliance. Key objectives include:
- Verification of antimicrobial effectiveness against target microorganisms
- Substantiation of antimicrobial performance claims
- Compliance with chemical safety and biocide regulations
- Quality control during production and finishing processes
- Buyer and brand performance requirements
Many markets regulate antimicrobial agents as biocidal substances, requiring both performance data and chemical safety assessments.
Testing ensures that antimicrobial-treated textiles deliver measurable microbial reduction while remaining compliant with applicable regulations.
Common Applications of Antimicrobial Textile Testing
Antimicrobial testing is widely applied to:
- Sportswear and activewear
- Socks and underwear
- Medical gowns, masks, and hospital textiles
- Bedding, towels, and upholstery
- Footwear linings and insoles
- Industrial and protective fabrics
Testing may be conducted on finished products, treated fabrics, or material samples during product development.
Antimicrobial Textile Testing Methods
Antimicrobial textile testing uses standardized microbiological techniques to evaluate bacterial or fungal reduction on treated fabrics compared to untreated controls.
Quantitative Antibacterial Activity Tests
These methods measure the percentage reduction of microorganisms after a defined contact time.
Common approaches include:
- Inoculating fabric samples with specific bacteria
- Incubating under controlled temperature and humidity
- Recovering and counting viable microorganisms
- Calculating microbial reduction rates
These tests provide numerical performance data commonly required for compliance documentation and marketing claims.
Qualitative Zone of Inhibition Tests
This method evaluates antimicrobial diffusion around treated textiles placed on agar plates.
Microbial growth inhibition zones indicate antimicrobial activity surrounding the fabric.
This approach is often used for screening purposes and product development evaluation.
Durability and Wash Resistance Testing
To assess long-term performance, antimicrobial testing may be conducted after repeated laundering cycles.
This simulates real-life use and evaluates whether antimicrobial effectiveness remains after washing.
Major Standards and Regulatory References
Antimicrobial textile testing is governed by international test methods, regional regulations, and buyer-specific protocols.
International Test Method Standards
ISO 20743
Determination of antibacterial activity of textile products using quantitative and qualitative methods. Widely adopted for antibacterial performance testing.
AATCC 100
Assessment of antibacterial finishes on textile materials using quantitative microbial reduction measurement.
AATCC 147
Qualitative antibacterial activity assessment using agar diffusion method.
JIS L 1902
Japanese standard for antibacterial activity testing of textiles, including absorption and printing methods.
European Regulatory Framework
Biocidal Products Regulation (BPR) (EU) No. 528/2012
Regulates antimicrobial substances used in treated articles, including textiles. Requires approval of active substances and proper labeling.
REACH Regulation (EC) No. 1907/2006
Controls chemical substances used in textile treatments, including antimicrobial agents.
China Regulatory Standards
GB/T 20944 Series
National standards for antibacterial performance testing of textiles, including quantitative and qualitative methods.
GB 18401
General textile safety regulation covering chemical safety requirements, applicable to antimicrobial-treated textiles.
Key Microorganisms Commonly Used in Testing
Antimicrobial textile testing frequently targets representative microorganisms such as:
- Staphylococcus aureus
- Escherichia coli
- Klebsiella pneumoniae
- Candida albicans (for antifungal testing)
The specific microorganisms used depend on standard requirements and intended product application.
Standard Selection Considerations
Choosing the appropriate antimicrobial test method depends on:
- Target market regulatory requirements
- Intended product function and claims
- Buyer performance specifications
- Required quantitative or qualitative data
- Durability and wash resistance expectations
Using recognized standards ensures that antimicrobial performance data is valid, comparable, and accepted by regulators and customers.
Compliance and Claim Substantiation
Antimicrobial performance claims such as:
- Antibacterial
- Odor-resistant
- Hygienic fabric
- Microbe-inhibiting
must be supported by laboratory test results based on recognized standards.
In regulated markets, improper or unsupported antimicrobial claims may lead to product withdrawal, penalties, or regulatory action.
Testing provides objective evidence to support compliance and market acceptance.
Antimicrobial textile testing is a critical component of performance verification and regulatory compliance for treated textile products.
Through standardized microbiological methods, manufacturers and brands can validate antimicrobial effectiveness, ensure chemical safety compliance, and meet buyer requirements across global markets.
With increasing regulatory oversight on antimicrobial substances and growing consumer demand for hygienic textiles, proper testing and documentation are essential for sustainable market access.
Antimicrobial Textile Testing Support
For antimicrobial textile testing services, method selection guidance, and compliance support, contact us at market@ecqa.com. Please provide product type, antimicrobial treatment details, intended market, and performance requirements to receive tailored testing solutions.
Request Free Sample Report